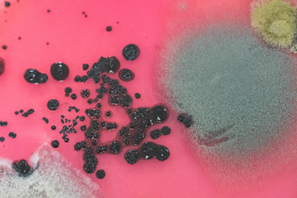

La réforme du bac et le programme d’enseignement scientifique du tronc commun de Terminale permet également d’impliquer les lycéens dans le développement de l’inventaire de la biodiversité du parc. Ainsi, les différentes méthodes d’inventaire (transect, quadra) et d’estimation des populations sont testées dans le parc avec les élèves lors d’activités pratiques. Nous avons, par exemple, estimé la population d’escargots turques (Helix lucorum) à 1400 individus dans la zone A, entre la médiathèque et le bâtiment St Pierre. Estimation qui sera à confirmer ou à préciser dans les années futures.

La filière de biotechnologie STL n’est pas en reste avec la recherche et la détermination des micro-organismes présents dans la terre du parc.
![]() |
![]() |